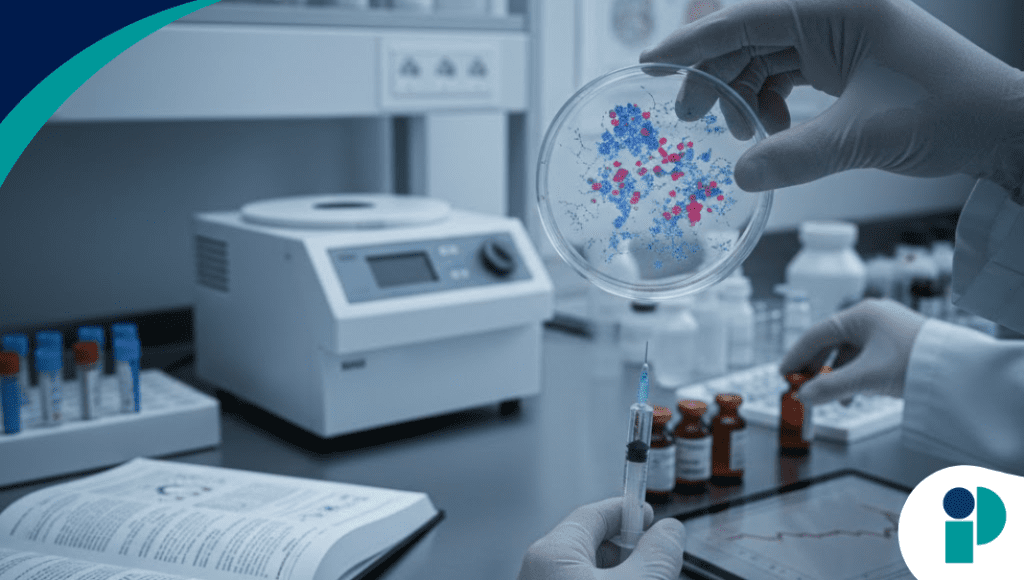
original web 2026 02 12t175151.389

Un ensayo clínico que evaluaba el uso de leucovorina (ácido folínico) en niños con trastorno del espectro autista (TEA) fue retractado el 29 de enero de 2026 por la revista European Journal of Pediatrics, del grupo Springer Nature, tras detectarse preocupaciones sustanciales sobre la validez de los datos y los análisis estadísticos.
La decisión editorial se produjo luego de una revisión posterior a la publicación que cuestionó la confiabilidad de los hallazgos reportados.
Diseño del estudio y resultados inicialmente reportados
La investigación, liderada por el neurólogo pediatra Indar Kumar Sharawat, MD, del All India Institute of Medical Sciences en Rishikesh (India), fue publicada el 7 de septiembre de 2024.
El ensayo, aleatorizado, doble ciego y controlado con placebo, incluyó a 77 niños con TEA y evaluó el efecto de la leucovorina oral durante 24 semanas.
Según los resultados originales, el grupo tratado presentó mejorías significativas en la Childhood Autism Rating Scale (CARS) frente al placebo (P < 0.001), lo que posicionó al fármaco como una posible alternativa terapéutica.
Posteriormente, investigadores y revisores externos plantearon inquietudes directamente al editor y mediante la plataforma PubPeer, señalando:
- Errores en los datos presentados en las tablas 2 y 3.
- Dudas sobre los métodos de análisis estadístico empleados.
La nota de retractación indicó: “La revisión estadística posterior confirmó varias de las preocupaciones y no logró replicar los resultados a partir del conjunto de datos proporcionado”.
En consecuencia, el editor concluyó que ya no existe confianza en la validez de los resultados ni en las conclusiones del artículo.
Contexto regulatorio: interés previo de la FDA
La retractación adquiere relevancia porque, en septiembre de 2025, la FDA había anunciado su intención de actualizar el etiquetado de la leucovorina para incluir información relacionada con el tratamiento de síntomas del autismo.
La leucovorina es un derivado del folato utilizado clínicamente para reducir la toxicidad de fármacos como el metotrexato y tratar la deficiencia cerebral de folato. Su uso en TEA, sin embargo, permanece fuera de indicación formal y con evidencia limitada.
Base biológica
El interés en esta terapia se sustenta en hallazgos que identifican autoanticuerpos contra la proteína FOLR1 en algunos pacientes con autismo.
Estos anticuerpos podrían:
- Interferir en el transporte de folato hacia el sistema nervioso central.
No obstante, revisiones recientes señalan que la evidencia que respalda este mecanismo es aún insuficiente.
La American Academy of Pediatrics (AAP) emitió orientación provisional en la que establece que no recomienda el uso rutinario de leucovorina en niños con TEA. De igual forma, la Coalition of Autism Scientists concluyó que existe evidencia científica limitada que sustente al fármaco como un tratamiento seguro y eficaz.
La neuróloga pediatra Shafali Jeste, MD, de la David Geffen School of Medicine at UCLA, advirtió: “Carecemos de datos sobre eficacia, seguridad o consecuencias a largo plazo”.
La especialista subrayó la necesidad de cautela clínica, especialmente ante reportes de:
- Efectos adversos.
- Ausencia de respuesta terapéutica.
- Incertidumbre en la toma de decisiones familiares.
Implicaciones para la investigación en autismo
La retractación refuerza la importancia de:
- Ensayos clínicos robustos.
- Transparencia en bases de datos.
- Reproducibilidad de resultados.
Particularmente en el campo del autismo, donde la necesidad de intervenciones efectivas basadas en evidencia sigue siendo prioritaria.
Fuente original aquí